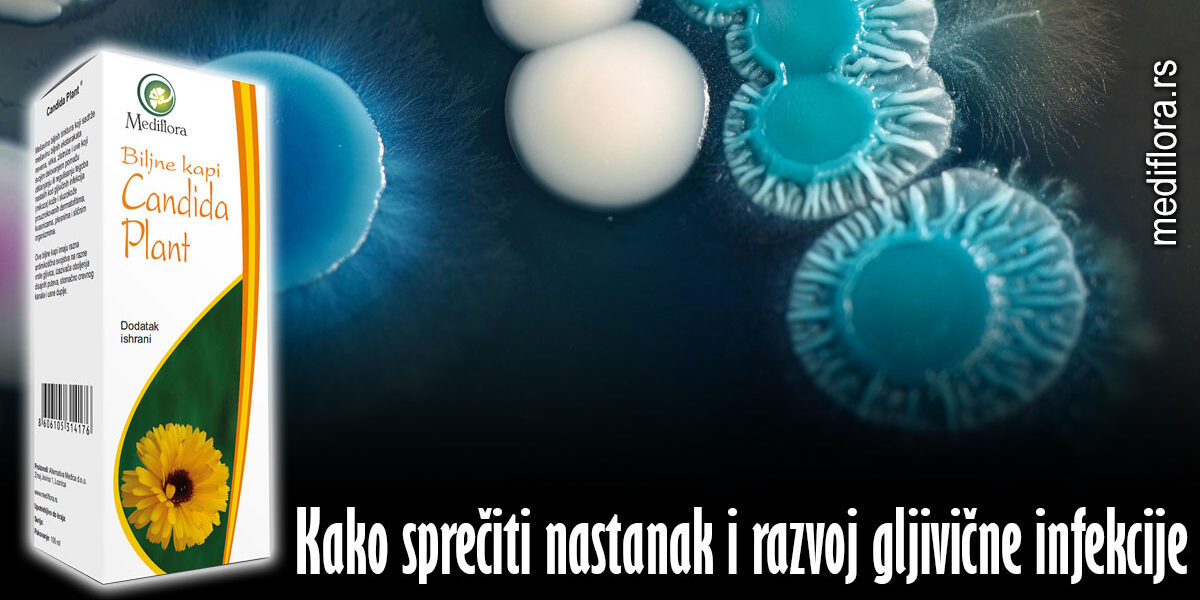
Kako sprečiti nastanak i razvoj gljivične infekcije

Da bi se sprečio razvoj „gljivica“ na nogama, treba dosledno poštovati mere higijene i izbegavati prekomerno izlaganje vlazi. Prilikom boravka na javnim mestima kao što su bazeni, svakako je neophodno nositi odgovarajuću obuću.
Kako sprečiti nastanak i razvoj gljivične infekcije
Gljivice se lako prenose i na članove porodice ili osobe s kojima oboleli deli kupatilo, bazen ili saunu. Infekcija ne prolazi sama od sebe i samo je pitanje vremena kada će s kože stopala preći na nokte. Najčešći simptom gljivične infekcije nokta je zadebljanje i promena boje nokta. Obično nema bolova niti drugih telesnih simptoma. Međutim, ako se ne leči, može doći do upale kože ispod i oko nokta što dovodi do pojave bolova.
Svrab između prstiju, ljuštenje kože, plikovi, bolni rezovi i neprijatan miris mogu biti znak gljivica na stopalima. Bolest se češće javlja kod ljudi koji se bave sportom, posebno kod trkača, fudbalera i plivača, i kod ljudi koji često nose obuću koja ne diše, odnosno patike, u protivnom gljivična bolest stopala može da se javi kod bilo koga.
Candida albicans pogađa 75% žena, a ni muškarci nisu pošteđeni
Visoki pH i promenjena vaginalna mikroflora može biti jedan od uzroka rizika za obolijevanje od polno prenosivih bolesti, tokom trudnoće može biti uzrokom pobačaja i prevremenog poroda, a može uzrokovati i upalne bolesti karlice. Čak 75 posto žena bar jednom u životu ima Candidu. Iako gljivice prirodno žive u našem probavnom i reproduktivnom sistemu, one isto tako mogu postati oportunistički patogeni i napasti te sisteme. Uzrok je sličan kao i kod bakterijske vaginoze, a radi se o poremećenoj ravnoteži mikroflore i rasta pH vrednosti. I muškarci mogu dobiti gljivičnu infekciju na polnom organu koju leče nanošenjem lokalnog antimikotika, ako su u odnosu kad je jedan partner zaražen, oba trebaju sprovoditi terapiju.
Upotrebom Candidaplant kapi izlečićeš gore navedene tegobe. Ne oklevaj, nego deluj već kod prvih simptoma.
Candidaplant kapi svojim jedinstvenim sastavom i bogatstvom prirodnih aktivnih supstanci uništavaju kandidu i zaustavljaju njen rast i razvoj, pomažu eliminaciji toksina iz organizma i regeneraciji sluzokože, čime sprečavaju mogućnost ponovnog prekomernog rasta kandide.
Candidaplant biljne kapi su moćan prirodni imunostimulator na bazi divljeg lekovitog bilja koje brzo podižu imunitet i broj belih krvnih zrnaca. Deluje protiv akutnih i hroničnih gljivičnih infekcija, bakterijskih infekcija, upala, jača prirodni imunitet tela na više nivoa.